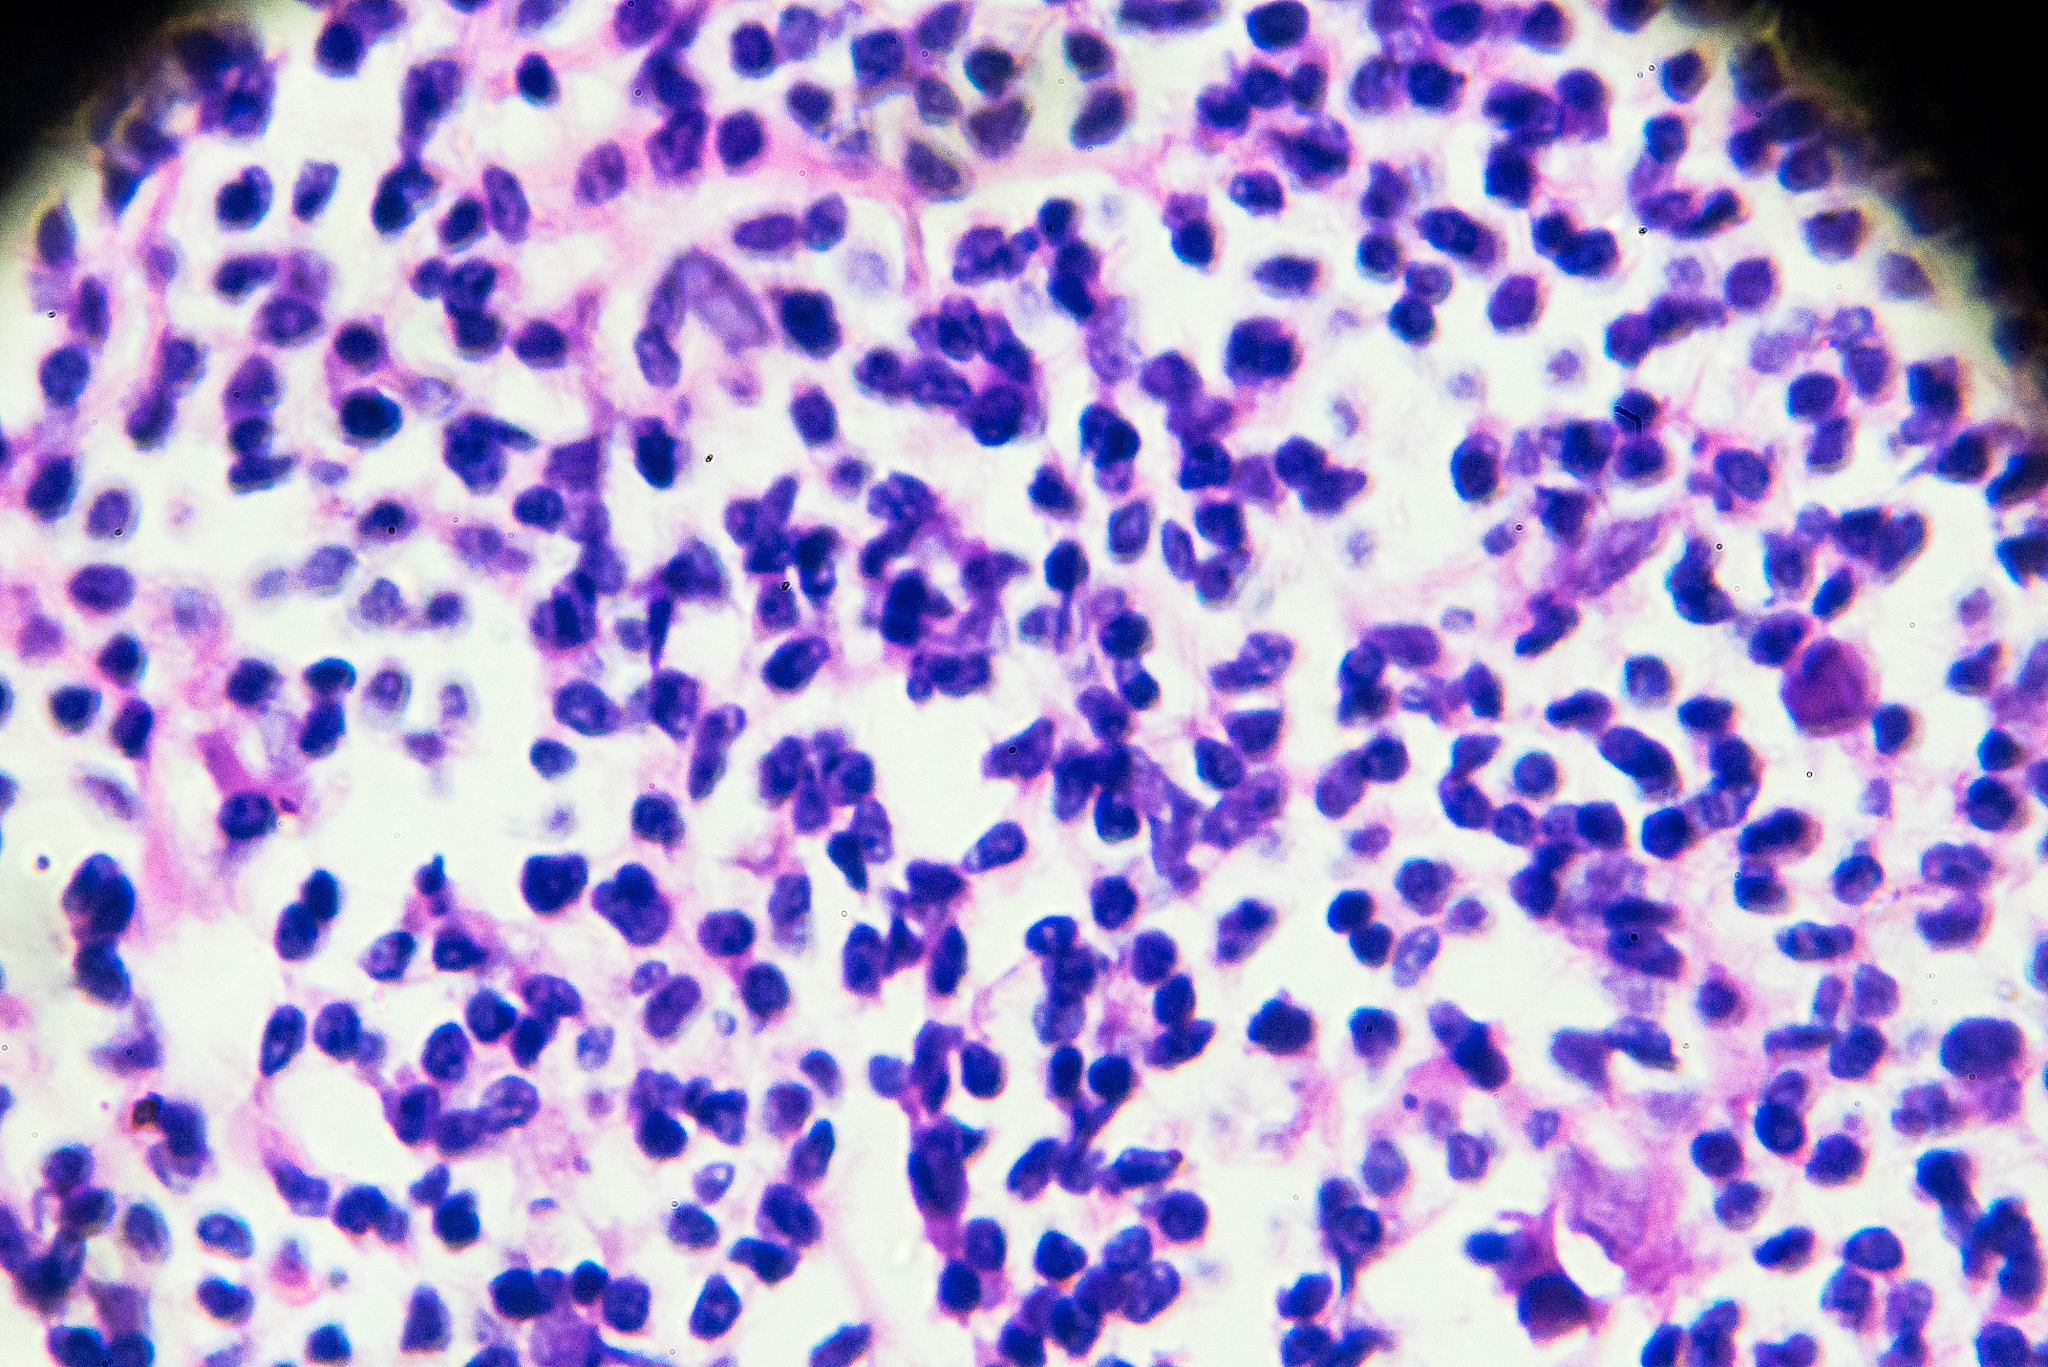
淋巴结增强轻度强化。这种情况是有问题吗

淋巴结增强轻度强化。这种情况是有问题吗
淋巴结的轻度强化可能是身体对感染或疾病的正常反应,通常不会有太大问题。然而,如果淋巴结持续增大、疼痛、红肿或出现其他症状,可能需要进一步检查和治疗。建议您咨询医生,以获取准确的诊断和指导。

原文地址: https://www.cveoy.top/t/topic/iVD8 著作权归作者所有。请勿转载和采集!
安全问答是一个知识全球问答,包含丰富的问答知识
淋巴结的轻度强化可能是身体对感染或疾病的正常反应,通常不会有太大问题。然而,如果淋巴结持续增大、疼痛、红肿或出现其他症状,可能需要进一步检查和治疗。建议您咨询医生,以获取准确的诊断和指导。
原文地址: https://www.cveoy.top/t/topic/iVD8 著作权归作者所有。请勿转载和采集!